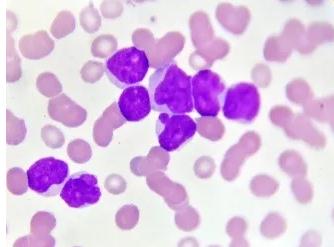
点击查看大图

比尔·班农(Bill Bannon)是明尼苏达州立法院的一名半退休法官。就在不久前,他刚刚打赢了人生中最重要的一场战役——这场战役发生的地方并不是比尔熟悉的法庭上,而是在他的身体里。
2年前,医生的一纸诊断掀开了战役的序幕。比尔病了,而且病得很严重。他患上的是急性髓系白血病(AML),在他的骨髓里,突变的细胞像野草一样疯长,正常的血细胞被压得抬不起头。比尔尝试了骨髓移植,接受了无数次化疗,却始终没能打败癌细胞。医生告诉比尔,传统的治疗手段已经无能为力了。想要活命,他只能到临床试验里碰碰运气。
这像极了所有AML患者生活的缩影。作为过去40年里研究进展最为匮乏的恶性血液癌症之一,患上这种疾病,就等于被提前宣判死刑。
显微镜下的不治之症
“血液粘稠、色似红酒、上有白膜”。1827年,人们对白血病有了最初的认识。随后20年间,更多相似病例的上报,引起了人们对这种疾病的关注。1845年,被誉为“现代病理学之父”的鲁道夫·魏尔肖(Rudolf Virchow)教授在显微镜下,第一次直观地看见了患者血液的异常:正常人的血液中,有色的“红血球”占据了绝大部分;但在白血病患者的血液里,充斥着大量无色或白色的小球体,白血病(leukemia)也因此得名。
很快,科学家们发现白血病不是一种简单的疾病,而是几种不同疾病的总称。根据病情恶化的速度,科学家们造出了“急性白血病”和“慢性白血病”两个词。而根据出现突变的血细胞来源,白血病又被分为“髓系白血病”和“淋巴细胞白血病”。之后的几十年里,科学家们又对白血病进行了更为详细的分类和分型,但搞清类别无助于白血病的治疗。对于这类顽疾,尤其是急性白血病,人们始终没有找到一种理想的治疗方案。白血病也在很长一段时间内,被认为是无解的绝症。
急性髓系白血病细胞(图片来源:123RF)
现代化疗的诞生
白血病治疗领域的一大突破,最初来自一场偶然的意外。在上世纪50年代,医生们发现给缺乏营养的病人补充叶酸,可以让他们的造血功能得到恢复。
这一下子就让人想到了白血病。前面我们提到,在白血病患者的血液里,大量无色或白色的小球体“挤掉”了红血球的位置,这看起来多么像是造血功能出现异常啊!那么让这些患者补充叶酸,是不是也能治疗白血病呢?
波士顿儿童医院的西德尼·法伯(Sidney Farber)医生决心测试这个想法。他招募了一批罹患急性白血病的儿童,并为他们注射了叶酸。随之,不幸的意外发生了,在病因尚未探明的半个多世纪前,贸然用药起到了截然相反的效果——叶酸不但没有阻止白血病的发展,反而加速了白血病的恶化。
痛定思痛,法伯医生提出了一个新的设想:既然给患者补充叶酸,会促进白血病的恶化。那么,反过来使用叶酸拮抗剂,来抑制叶酸的作用,是不是就可以治疗白血病呢?这一次,幸运女神向他露出了微笑。使用一种叫做氨基喋呤(aminopterin)的药物,法伯医生成功缓解了白血病的病情,也首度让人们看到了治疗白血病的希望。
用现在的角度看,氨基喋呤是一种化疗药物。因此,法伯医生也被尊称为“现代化疗之父”。他的发现,开辟了白血病治疗的新纪元。
从“黄金疗法”到骨髓移植
尽管法伯医生最初治疗的是另一种白血病,这并不妨碍化疗在AML的治疗中开花结果。其中,一种被称为“7+3”的疗法脱颖而出,受到了大量医生们的欢迎。具体来看,这种疗法由两类化疗药物组成,一类是阿糖胞苷(使用7天),另一类常为柔红霉素(使用3天),“7+3”疗法也因此得名。
在过去的40年里,这种化疗方法被广泛用于AML的治疗。从效果上看,它能极大地降低患者在确诊早期的死亡率。对于30岁以下的年轻患者,这一疗法还能取得非常高的总体治愈率。在治疗后,能够存活10年以上的患者超过六成!因此,它也被称作是治疗AML的“黄金疗法”。
但黄金疗法也有它的局限。高强度的化疗虽然能有效地杀伤癌细胞,却也会给患者带来极为严重的毒副作用。一项统计表明,如果患者年龄超过了75岁,那么在接受治疗的30天内,患者的死亡率高达三分之一!因此,这种疗法也难称完美。
化疗之外,另一些科学家则在其他领域寻找治疗白血病的希望。20世纪60年代,首例人体肾移植大获成功给科学家带来了灵感。科学家不禁设想:既然器官可以移植,那么由骨髓产生的造血细胞呢?如果先用什么方法杀死作恶的癌细胞,再将正常造血细胞移植进患者体内,不就能使他们的血液恢复正常,实现治愈疾病的目的了吗!
美国科学家唐纳尔·托马斯(Edward Donnall Thomas)教授是将这个想法付诸于实践的第一人。不幸的是,他的尝试一开始就遭遇了挫折,在第一批进行骨髓移植的6名患者中,只有2名顺利完成了移植,并且他们都没能活过100天。在之后的试验中,骨髓移植也没有如理论设想的那般顺利发展。从1969年到1974年,接受移植的54位患者没有一名能够长期存活……移植后的感染、排斥反应和凝血异常,都有可能危及患者生命。
成功率持续没有起色,让当时的主流观点把骨髓移植看作是白血病治疗的一种无奈之举,也让患者和医生闻之色变。但托马斯教授并没有因此放弃。尽管54例试验全部以失败告终,但其中6位患者的白血病症状曾短暂地完全消失,这让他依旧保有一丝希望。
随着临床经验的积累,医生们发现术后感染和排斥反应是导致试验失败的主要原因,为此他们不断改善骨髓移植的操作程序,并提高手术的环境和条件。比如:把移植后的患者安置在无菌病房;输注从马身上得到的抗胸腺细胞球蛋白来抑制排异反应;将实验室搬入当时设备先进的癌症研究中心。
短短3年后,接受移植的晚期急性白血病患者的生存率终于从0提高到了13%,跨出了从无到有的第一步!此后骨髓移植对白血病的治疗效果逐步提升。到上世纪70 年代末,超过一半接受骨髓移植的患者重获健康。对治疗方法有限的AML患者而言,骨髓移植更是成为了治疗的“终极大招”。
1988年欧洲骨髓移植研究组织统计的AML患者骨髓移植后无病生存率(图片来源:诺贝尔奖官网)
可并不是所有患者都能受益于骨髓移植。在实际操作上,医生们往往会先用化疗或放疗来清除患者体内的癌细胞。但这些方法“敌我不分”,会对身体造成极大的负担,不是每一名患者都可以承受。而对于癌细胞没有被清除干净的患者,骨髓移植也不能带给他们帮助。另外,即使在治疗条件成熟的今天,骨髓移植也是一种高风险性的手术,存在一定手术失败和术后复发风险。
对AML治疗的探索又一次走进了困局。
如流星闪过的“魔法子弹”
很少有恶性疾病的治疗方法多年保持不变,AML是其中的例外。在之后长达数十年的时间里,化疗和骨髓移植是AML患者为数不多的选择,耐受性差、复发率高依然是悬在AML患者头上的达克摩斯之剑。综合来看,患者的5年生存率仅有27%,如果是60岁以上的老年患者,5年生存率更是不到10%,令人绝望。
上世纪80年代之后,分子生物学的快速进步,让科学家们在微观世界的探索中取得了新发现。他们找到了一种特殊的蛋白CD33,它只存在于骨髓性白血病细胞上,健康造血细胞上却没有它的身影。如果以CD33蛋白为靶发射一颗子弹,就不会发生放、化疗下“敌我不分”的情况,而能实现对白血病细胞的精准打击。
Mylotarg(gemtuzumab ozogamicin)的分子结构(图片来源:ADCReview.com)
沿着这个思路科学家们不断钻研,得到了专杀AML细胞的“魔法子弹”Mylotarg。它是由抗CD33蛋白单克隆抗体和卡奇霉素两部分组成的抗体偶联药物,前者可以与CD33蛋白结合,发挥定位的作用;后者是具有强毒性的细胞毒素,发挥子弹的作用。
早期的临床试验表明,相对其副作用,Mylotarg给患者带来的疗效更为显着。总的来看,30%患者体内的血细胞能够恢复正常。更让人惊喜的是,在5年生存率极低的60岁以上老年患者中,有超过四分之一可从Mylotarg的治疗中获益。
2000年,在肿瘤药物咨询委员会的建议下,FDA加速批准Mylotarg上市,用于治疗60岁以上,首次出现复发的AML患者。对于经不住化疗的患者来说,这无疑是个令人欣喜的好消息!然而,在上市后进行的更大规模临床试验中,“魔法子弹”的“魔法”不再那么神奇。数据显示,Mylotarg与化疗联用,并没有取得比单独化疗更显着的疗效。同时,它的副作用也出现了增加。剧情急转直下,让Mylotarg在获批10年后黯然离开市场。
对症下药的幕后功臣
幸运的是,科学家们从未停下对AML的探索。当业界陷入困顿的时候,基础科学的进步让人们对疾病治疗有了新的认知。2008年,科学家们对一位AML患者的基因进行了测序,通过与正常基因组进行比对,科学家们最终发现10个可能与AML形成和进展有关的基因突变。值得一提的是,这也是人类首次对癌症基因组进行完全DNA测序。这一开创性工作,为科学家更好的找到癌症基因,并对症下药提供了新思路。
此后,随着全基因组测序技术的发展,研究人员在更大量的样本中,发现了与AML进展有关,或影响AML预后的基因突变,针对其中关键突变的靶向药物研发也进入了快车道。2017年之后,停滞了40年的AML治疗终于迎来了曙光。
冲破黑暗的“第一道光”,是针对FLT3基因突变的靶向药物Rydapt。在所有AML患者中,有25-30%的比例携带FLT3基因突变。作为一种激酶,当FLT3发生突变时,往往会加速白血病病情的发展,同时增加疾病复发的风险。通过抑制FLT3,Rydapt能够控制癌细胞的生长,甚至诱导癌细胞死亡。
图片来源:诺华官方网站
临床试验证实了这一点。科学家们发现,同时使用Rydapt与化疗,可以明显延长患者的生命,使他们的死亡风险降低23%!基于这些结果,FDA批准Rydapt上市治疗带有FLT3基因突变的AML患者。这也体现了基因检测对于药物研发和疾病治疗的重要性。
快一点,再快一点
沿袭精准治疗理念,更多新药在研发人员们的努力下加速诞生,来到了患者身边。在Rydapt获批的短短几个月后,由新基(Celgene)与Agios公司合作研发的Idhifa也获批上市,这款新药针对的靶点是突变的IDH2蛋白。IDH2蛋白是一种酶,在人体细胞能量代谢中起到了重要催化作用。IDH2基因突变会抑制正常的血细胞发育,导致过多不成熟的血细胞产生。在AML中大约有8%-19%的患者带有IDH2突变。
Idhifa是一种IDH2抑制剂,也是首个上市的致癌代谢物合成抑制剂,通过阻断发生突变的IDH2蛋白,间接起到抑制肿瘤作用。临床试验表明,在疾病出现复发、且缺乏有效疗法的AML患者中,有23%的比例在Idhifa的治疗下,血细胞可以完全恢复正常。要知道在此之前,AML多次复发几乎和死亡划等号!
基于临床中的优异表现,Idhifa曾被FDA授予突破性疗法认定,并于2017年8月经优先审评批准上市。2018年,Idhifa还斩获了有“医药界诺贝尔奖”之称的盖伦奖,以表彰它为改善人类健康做出的杰出贡献。作为Agios的长期合作伙伴,药明康德也非常高兴能够协助加速Idhifa的上市,让它造福更多患者。
图片来源:盖伦基金会官网
在Rydapt和Idhifa相继上市之后,AML治疗领域迎来了药物大爆发。截止2018年底,AML新药数量已经达到8个,其中既包括多个获突破性疗法认定的靶向药物,也有40年来化疗领域的重大突破,给AML患者群体的生存状态带来了改善。
结语
让我们回到故事的开篇。在最初接受骨髓移植后,比尔的症状一度曾得到过有效控制。但不久后,容易复发的AML又卷土重来,将他逼到了死亡的悬崖边。更可怕的是,比尔被确诊带有FLT3基因突变,这意味着他的病情进展会比其他AML患者更快。作为生命的最后一搏,在医生的推荐下,比尔参加了一项针对FLT3突变的新药临床试验。如果这款新药不起效,他的生命将只剩下最后几个月,最多也不超过一年。
但比尔是幸运的。复查结果发现,这款还在研究之中的新药分子成功杀死了癌细胞。移植入他体内的健康细胞,也成功地从AML的复发中存活了下来。如今,比尔的体内只能检测到很少的FLT3基因突变。来自捐赠人的细胞,正在他体内源源不断地生成新的后代,让比尔得到了治愈。
化疗、骨髓移植、靶向药物……比尔的故事本身就是半个多世纪来人类智慧的结晶。在见证科学奇迹的同时,我们也对未来充满期望——目前能够得到有效治疗的患者,比例还不是非常高。面对未来,依然存在大量未竟医疗需求亟待满足。为此,我们也期待携手同仁,继续不懈探索,将更多创新疗法带给全球病患。
参考资料:
[1] Piller G J . Leukaemia - A brief historical review from ancient times to 1950[J]. British Journal of Haematology, 2001, 112(2):282-292.
[2] History of Dana-Farber Cancer Institute,from https://www.dana-farber.org/about-us/history-and-milestones/
[3]Lichtman M A. A historical perspective on the development of the cytarabine (7days) and daunorubicin (3days) treatment regimen for acute myelogenous leukemia: 2013 the 40th anniversary of 7+3.[J]. Blood Cells Mol Dis, 2013, 50(2):119-130.
Thomas ED; Buckner CD; Banaji M; Clift RA; Fefer A; Flournoy N; Goodell BW; Hickman RO; Lerner KG; Neiman PE; Sale GE; Sanders JE; Singer J; Stevens M; Storb R; Weiden PL. One hundred patients with acute leukemia treated by chemotherapy, total body irradiation, and allogeneic marrow transplantation.[J]. Blood, 1977, 49(4):511-533.
[4]Thomas E D, Sanders J E, Flournoy N, et al. Marrow transplantation for patients with acute lymphoblastic leukemia in remission[J]. Blood, 1979, 54(2):468-76.
[5]17年跌宕起伏,首个治疗白血病的抗体偶联药物终现昔日荣光,5 年存活率提升 20% ,September 4,2017,
from http://www.myzaker.com/article/595b31d81bc8e0471300000c/
[6] 25年来白血病治疗首个重大突破!诺华靶向疗法今日获批,April 29, 2017, from https://mp.weixin.qq.com/s?__biz=MzAwMDA5NTIxNQ==&mid=2649961266&idx=2&sn=8a94c0987248e12a2820464701c57027&chksm=82e9b5b2b59e3ca424ee22dfa9f7cbf85ea35bf6f17bca8bb8452317aa4fb9425afe95fce80d#rd
[7] 祝贺!“医药界诺贝尔奖”揭晓,Agios/新基新药获最佳药品奖, Retrieved November 30, 2018, from https://zhuanlan.zhihu.com/p/47897635
[8] United States Patent 9,512,107, Retrieved December 6, 2016, from http://patft.uspto.gov/netacgi/nph-Parser?d=PALL&p=1&u=%2Fnetahtml%2FPTO%2Fsrchnum.htm&r=1&f=G&l=50&s1=9512107.PN.&OS=PN/9512107&RS=PN/9512107
来源:药明康德
为你推荐
资讯 助力国家人工智能应用中试基地建设,蚂蚁阿福上线樊嘉院士肝病专科智能体
3月28日,国家人工智能应用中试基地(医疗领域)阶段性成果总结发布会在复旦大学附属中山医院举行。
2026-03-29 21:03
资讯 贵州百灵的“平账”造假行为
3月28日,贵州百灵(ST百灵,002424 SZ)发布多则公告披露,公司及相关当事人已分别收到贵州证监局下发的《行政处罚决定书》,涉及连续四年年报虚假记载、相关人员违规履职等多...
2026-03-29 19:38
资讯 李强主持召开国务院常务会议,研究加快建设分级诊疗体系有关政策措施
要统筹抓好分级诊疗体系建设和医疗卫生强基工程实施,以常见病、慢性病为重点引导群众基层首诊,以增强就医连续性为导向优化转诊服务管理,扎实做好家庭医生签约服务,推动医疗...
2026-03-28 22:18
资讯 百度智能云加码银发经济:大模型破解养老供需错配难题
当居家养老还停留在“人找服务”的传统模式时,以大模型与AI Agent为代表的智能技术,正在掀起一场全新变革,服务开始主动理解需求,并精准触达每一位老人。
2026-03-27 17:24
资讯 优赫得序贯THP方案在华获批用于HER2阳性早期乳腺癌新辅助治疗,实现该适应症“全球首发”
此次获批使优赫得®迈向早期乳腺癌,成为首个且唯一*获批HER2阳性乳腺癌新辅助治疗的ADC疗法
2026-03-27 17:16
资讯 医疗服务价格项目立项指南解读辅导(第1期)
长期以来,医疗服务价格实行属地管理,由地方医药价格主管部门制定价格项目、确定价格水平,地区间价格项目数量、内涵、颗粒度差异较大,部分地区按操作流程、岗位分工等拆分价...
2026-03-27 11:21
资讯 社保“第六险”,长期护理险全国落地
3月25日,中共中央办公厅、国务院办公厅发布《关于加快建立长期护理保险制度的意见》,标志着这项被称作社保“第六险”的制度正式结束10年试点,迈向全国建制新阶段。
2026-03-26 18:09
资讯 国家药监局发布《药品现代物流规范化建设指导意见》,自发布之日起施行
本指导意见是对申请开办药品批发企业(以下简称批发企业)和接受委托储存运输药品业务的第三方药品现代物流企业(以下简称第三方物流企业),在药品现代物流设施设备等方面的基...
2026-03-26 10:14
资讯 华东医药独家商业化VC005片Ⅲ期临床顶线数据积极,抢占自免口服疗法新高地
华东医药战略合作方江苏威凯尔医药科技股份有限公司(简称“江苏威凯尔”)宣布,其自主研发的Ⅱ代高选择性JAK1抑制剂VC005片在口服治疗中重度特应性皮炎(AD)的Ⅲ期临床研究中...
2026-03-25 18:52
资讯 Cytiva携手上海临床研究中心与新叶生维, 加速先进细胞治疗临床应用转化与产业化发展
Cytiva与上海临床研究中心签署战略合作备忘录,共同设立先进细胞治疗技术临床应用示范平台,以产学研协同为牵引,带动区域产业升级。
2026-03-25 18:46
资讯 国家药监局批准两款创新医疗器械
近日,国家药品监督管理局批准了两款创新医疗器械上市。分别为阿迈特医疗器械(北京)股份有限公司二氧化碳造影压力注射套装创新产品注册申请和应脉医疗科技(上海)有限公司经...
2026-03-25 14:53
资讯 甘李药业博凡格鲁肽新适应症获批IND
近日,甘李药业股份有限公司及其全资子公司甘李药业山东有限公司宣布,其自主研发的博凡格鲁肽(研发代号:GZR18)注射液增加新适应症的临床试验申请获得国家药监局批准。拟用于...
2026-03-25 14:38
资讯 茵菲多组学完成5100万元Pre-A轮融资,构建“硬件+AI+试剂”一体化技术壁垒
本轮融资由杭州新干世业、三泽资本、泰煜投资、德华创投共同参与,丰和资本担任独家财务顾问
2026-03-24 12:59